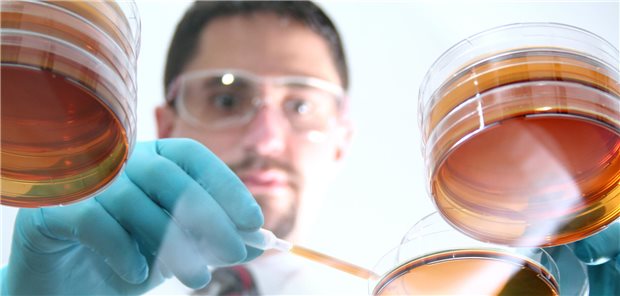
Mann for Petrischalen

Pflegende Angehörige
Hilfe für die Helfer
Das Gros der Pflegebedürftigen in Deutschland wird von Angehörigen betreut. Damit der ständige Bereitschaftsdienst für den Ehemann, den Vater oder die Schwiegermutter nicht in totaler Erschöpfung endet, steht die AOK zur Seite.